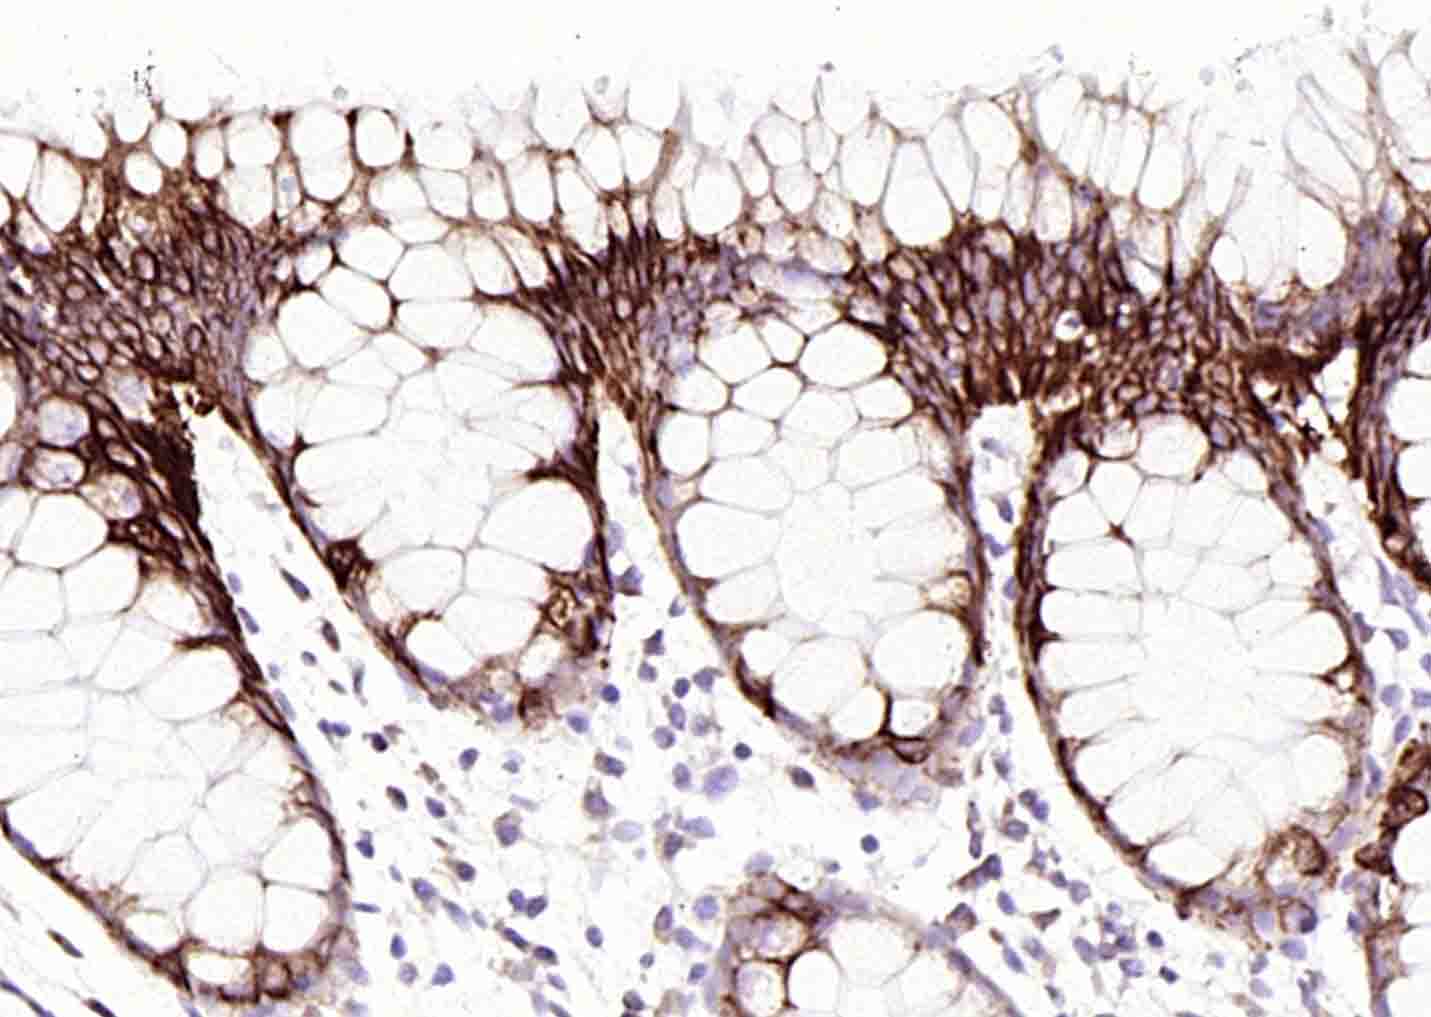
细胞角蛋白20抗体-bsm-34154M
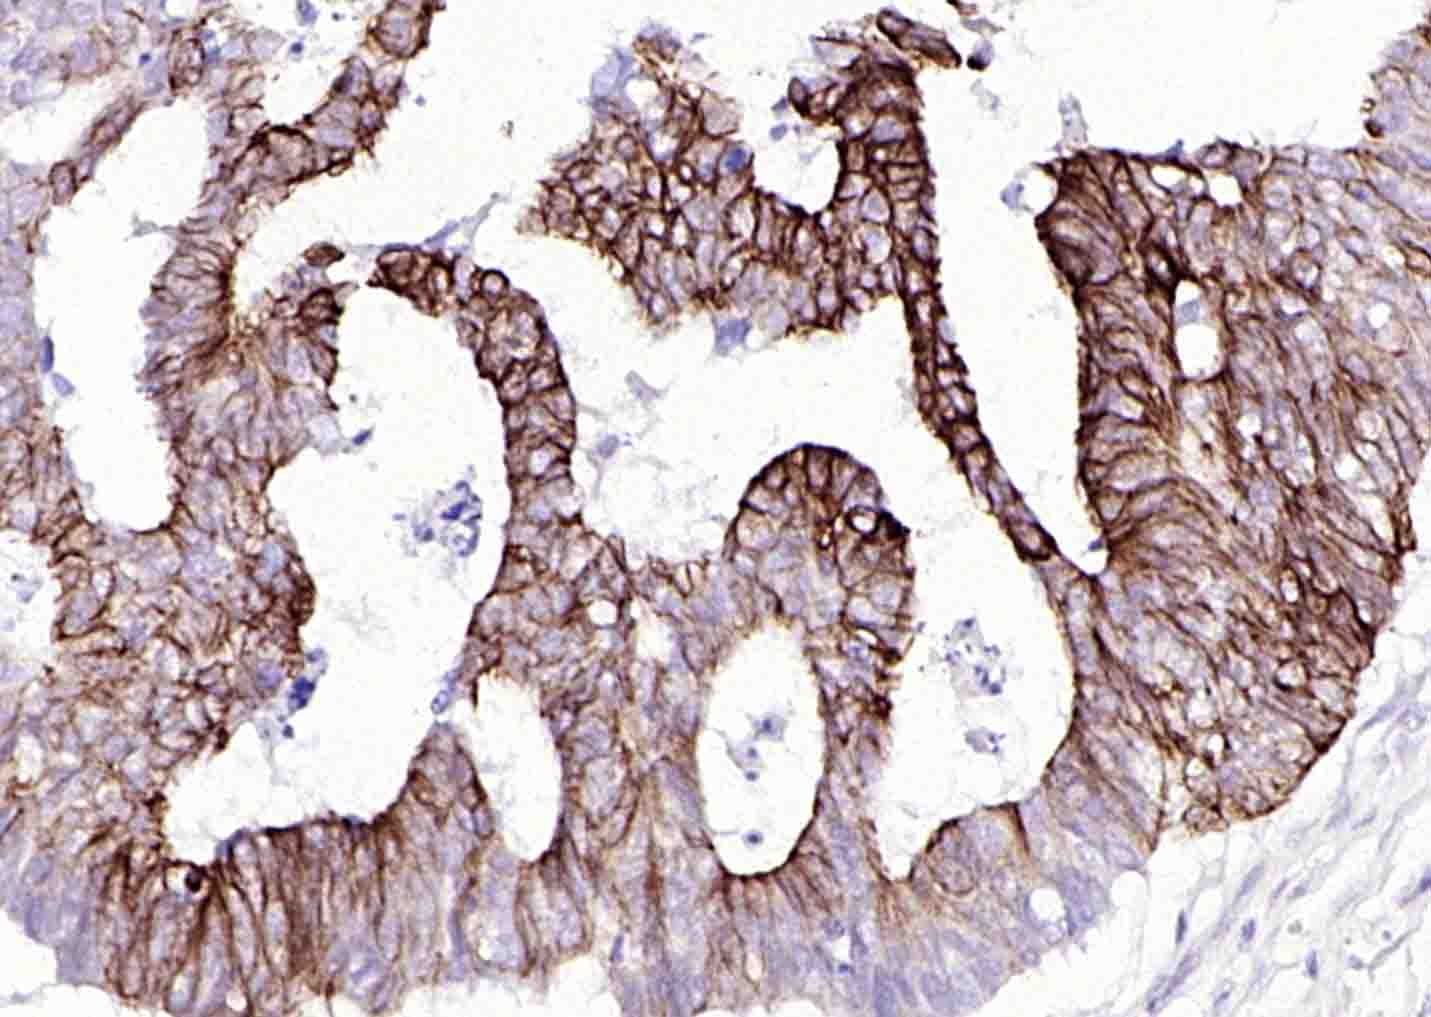
细胞角蛋白20抗体-bsm-34154M

Cytokeratin 20 Mouse mAb (一抗) - IHC-P,IHC-F,IF | Bioss

货号:bsm-34154M
产品详情
相关标记
相关产品
相关文献
常见问题
概述
产品编号
bsm-34154M
产品类型
病理级抗体、mIHC精品抗体
英文名称
Cytokeratin 20 Mouse mAb
中文名称
细胞角蛋白20抗体
英文别名
CD20; CK-20; CK20; K20; KRT21; 9030623C06Rik; K1C20_HUMAN; KRT20; Cytokeratin-20 (CK-20); Keratin-20 (K20); Protein IT; K1C20_MOUSE; K1C20_RAT; Cytokeratin-21 (CK-21);
抗体来源
Mouse
免疫原
KLH conjugated synthetic peptide derived from human CK20
亚型
IgG2b,k
性状
Liquid
纯化方法
affinity purified by Protein A
克隆类型
Monoclonal
克隆号
18F9
理论分子量
48 kDa
浓度
1mg/ml
储存液
Liquid in PBS containing 50% Glycerol, 0.5% BSA and 0.02% Proclin300.
研究领域
SWISS
Gene ID
保存条件
Shipped at 4℃. Store at -20℃ for one year. Avoid repeated freeze/thaw cycles.
注意事项
This product as supplied is intended for research use only, not for use in human, therapeutic or diagnostic applications.
数据库链接
产品介绍
结构蛋白(Structural Proteins)
CK-20细胞角蛋白-20主要用于肿瘤方面的研究,近年来大多用于消化系统恶性肿瘤的鉴别,主要在胞浆。
CK-20细胞角蛋白-20主要用于肿瘤方面的研究,近年来大多用于消化系统恶性肿瘤的鉴别,主要在胞浆。
背景资料
Cytokeratin 20 is a type I keratin which is primarily expressed in gastric and intestinal epithelium, urothelium, and Merkel-cells. The keratins are intermediate filament proteins responsible for the structural integrity of epithelial cells and are subdivided into cytokeratins and hair keratins. The type I cytokeratins consist of acidic proteins which are arranged in pairs of heterotypic keratin chains. Their genes are clustered in a region of chromosome 17q12-q21. Cytokeratin 20 is a major cellular protein of mature enterocytes and goblet cells and is specifically expressed in the gastric and intestinal mucosa. It is also expressed in adenocarcinomas of the colon, stomach, pancreas and the bile system and is present in mucinous ovarian tumors, transitional-cell and Merkel-cell carcinomas. Notably, the squamous cell carcinomas and adenocarcinomas of the breast, lung, and endometrium, non-mucinous tumors of the ovary, and small cell carcinomas lack cytokeratin 20.

产品应用
| 应用 | 已检合格种属 | 预测种属 | 推荐稀释比例 |
|---|---|---|---|
| IHC-P | Human, Mouse, Rat | 1:100-500 | |
| IHC-F | Human, Mouse, Rat | 1:100-500 | |
| IF | Human, Mouse, Rat | 1:100-500 |
交叉反应
交叉反应: Human, Mouse, Rat
相关产品
暂无相关产品
靶标
基因名
KRT20
蛋白名
Keratin, type I cytoskeletal 20
亚基
Heterotetramer of two type I and two type II keratins. Associates with KRT8.
亚细胞定位
Cytoplasm.
组织特异性
Expressed predominantly in the intestinal epithelium. Expressed in luminal cells of colonic mucosa. Also expressed in the Merkel cells of keratinized oral mucosa; specifically at the tips of some rete ridges of the gingival mucosa, in the basal layer of the palatal mucosa and in the taste buds of lingual mucosa.
翻译后修饰
Hyperphosphorylation at Ser-13 occurs during the early stages of apoptosis but becomes less prominent during the later stages. Phosphorylation at Ser-13 also increases in response to stress brought on by cell injury (By similarity).
Proteolytically cleaved by caspases during apoptosis. Cleavage occurs at Asp-228.
Proteolytically cleaved by caspases during apoptosis. Cleavage occurs at Asp-228.
相似性
Belongs to the intermediate filament family.
功能
Plays a significant role in maintaining keratin filament organization in intestinal epithelia. When phosphorylated, plays a role in the secretion of mucin in the small intestine (By similarity).
同靶标产品
相关文献
提示: 发表研究结果有使用 bsm-34154M 时请让我们知道,以便我们可以引用参考文章。作为回馈,资料提供者将获得我们送上的小礼品。